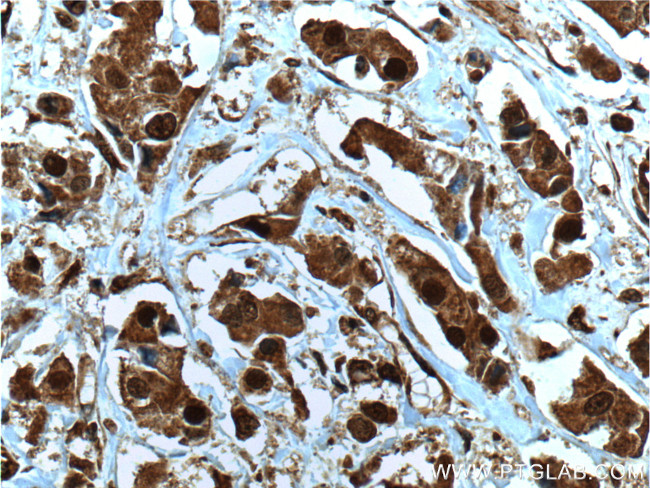
NOB1 Antibody in Immunohistochemistry (Paraffin) (IHC (P))

Search
Proteintech
NOB1 Monoclonal Antibody (8C11A12)
{{$productOrderCtrl.translations['antibody.pdp.commerceCard.promotion.promotions']}}
{{$productOrderCtrl.translations['antibody.pdp.commerceCard.promotion.viewpromo']}}
{{$productOrderCtrl.translations['antibody.pdp.commerceCard.promotion.promocode']}}: {{promo.promoCode}} {{promo.promoTitle}} {{promo.promoDescription}}. {{$productOrderCtrl.translations['antibody.pdp.commerceCard.promotion.learnmore']}}
产品信息
66048-1-IG
种属反应
宿主/亚型
分类
类型
克隆号
抗原
偶联物
形式
浓度
规格
纯化类型
保存液
内含物
保存条件
运输条件
产品详细信息
Immunogen sequence: SSFMFWRNP LPNIDHELQE LLIDRGEDVP SEEEEEEENG FEDRKDDSDD DGGGWITPSN IKQIQQELEQ CDVPEDVRVG CLTTDFAMQN VLLQMGLHVL AVNGMLIREA RSYILRCHGC FKTTSDMSRV FCSHCGNKTL KKVSVTVSDD GTLHMHFSRN PKVLNPRGLR YSLPTPKGGK YAINPHLTED QRFPQLRLSQ KARQKTNVFA PDYIAGVSPF VENDISSRSA TLQVRDSTLG AGRRRLNPNA SRKKFVKKR (36-293 aa encoded by BC000050)
靶标信息
In yeast, over 200 protein and RNA cofactors are required for ribosome assembly, and these are generally conserved in eukaryotes. These factors orchestrate modification and cleavage of the initial 35S precursor rRNA transcript into the mature 18S, 5.8S, and 25S rRNAs, folding of the rRNA, and binding of ribosomal proteins and 5S RNA. Nob1 is involved in pre-rRNA processing. In a late cytoplasmic processing step, Nob1 cleaves a 20S rRNA intermediate at cleavage site D to produce the mature 18S rRNA.
仅用于科研。不用于诊断过程。未经明确授权不得转售。
篇参考文献 (0)
生物信息学
蛋白别名: adenocarcinoma antigen recognized by T lymphocytes 4; ART-4; nin one binding protein; NIN1/PSMD8 binding protein 1 homolog; Phosphorylation regulatory protein HP-10; Protein ART-4; PSMD8 binding protein 1; RNA-binding protein NOB1; unnamed protein product
基因别名: ART-4; ART4; MST158; MSTP158; NOB1; NOB1P; PSMD8BP1
UniProt ID: (Human) Q9ULX3
Entrez Gene ID: (Human) 28987